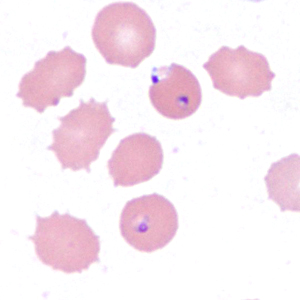
Case385_F.jpg

Case #385 – December 2014
A 10-year-old girl residing in Pennsylvania was hospitalized with a 101.5º F fever, vomiting, abdominal pain, and diarrhea. The patient had recently returned from visiting family in West Africa. A blood specimen was collected in EDTA and sent to the hematology lab for routine work-up, including preparation of thick and thin films for malaria diagnosis. Suspect organisms were seen by the attending hematologist. The slides were forwarded on to the state health lab, whose microbiologist took digital images and sent them to the DPDx Team for diagnostic assistance. Figures A-F show four of the images received for consultation. What is your diagnosis? Based on what criteria?

Figure A

Figure B

Figure C

Figure D

Figure E
Figure F
This case and images were kindly provided by the Pennsylvania Department of Health, Exton, PA.
Images presented in the DPDx case studies are from specimens submitted for diagnosis or archiving. On rare occasions, clinical histories given may be partly fictitious.
DPDx is an educational resource designed for health professionals and laboratory scientists. For an overview including prevention, control, and treatment visit www.cdc.gov/parasites/.